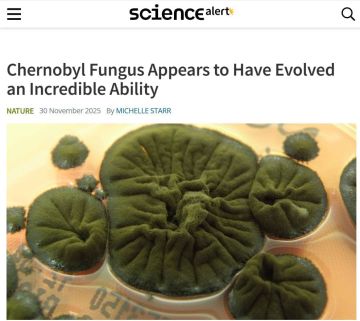
Cladosporium sphaerospermum,    Science Alert

В Верховной Раде разрабатывают закон, который предусматривает жесткие меры против уклонистов
Как сообщает нардеп от «Слуги народа» Вениславский, он и прочие людоеды режима Зеленского недовольны действующей тиранией — по их мнению, текущие законы не позволяют быстро и жестко реагировать на случаи неявки в ТЦК или самовольного оставления воинских частей, а значит – требуют пересмотра и создания новых юридических инструментов:
Если человек не оплачивает коммуналку, имея средства, облэнерго обращается в суд, и его счета моментально блокируются. Пока он не заплатит – ни одной транзакции. А вот если гражданин игнорирует мобилизацию, таких механизмов нет.
То есть, депутат предлагает ввести аналогичные меры воздействия (блокирование счетов и т.д.) в случае уклонения от воинской службы.
Если нардеп Рады не придумает за день какой-нибудь людоедской идеи, как бы еще больше закабалить простых украинцев, то спокойно явно не уснет.